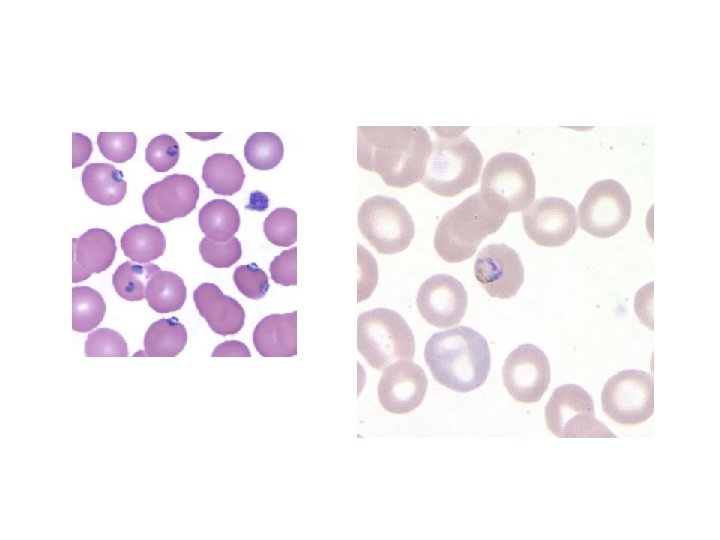

OLEH NURHALINA SKM M EPID ANALIS KESEHATAN Prevalensi

- Slides: 30
OLEH ; NURHALINA, SKM, M. EPID ANALIS KESEHATAN
Prevalensi malaria • Direktur Pengendalian Penyakit Bersumber Binatang Kementerian Kesehatan Andi Muhadir mengatakan prevalensi penyakit malaria di Indonesia masih tinggi, mencapai 417. 819 kasus positif pada 2012. • 70 persen kasus malaria terdapat di wilayah Indonesia Timur, terutama di diantaranya Papua, Papua Barat, Maluku, Maluku Utara, Sulawesi dan Nusa Tenggara. • Wilayah endemik malaria di Indonesia Timur tersebar di 84 kabupaten/kota dengan jumlah penduduk berisiko 16 juta orang • faktor geografis yang sulit dijangkau dan penyebaran penduduk yang tidak merata merupakan beberapa penyebab sulitnya pengendalian malaria di wilayah itu.
Current issue • Peneliti AS Temukan Cara Produksi Obat Anti-Malaria Secara Murah • WHO: Jumlah Kematian akibat Malaria Turun 30 Persen • WHO: Jumlah Dana Pemberantasan Malaria Jauh dari yang Diharapkan • WHO: Malaria di Asia Tenggara Semakin Kebal terhadap Obat • WHO: Malaria Masih Mengancam • Dokter Indonesia dan ASEAN Bisa Resepkan Obat Tradisional Mulai 2015
Parasit malaria • Plasmodium adalah jenis parasit yang menyebabkan malaria. Ada banyak sekali jenis parasit Plasmodium, tapi hanya lima jenis yang menyebabkan malaria pada manusia. Parasit Plasmodium hanya disebarkan oleh nyamuk Anopheles betina. Gigitan ini lebih sering terjadi pada malam hari. Melalui gigitan nyamuk, parasit masuk ke dalam aliran darah manusia.
PARASIT MALARIA 1. 2. 3. 4. 5. Plasmodium Falcifarum Plasmodium Vivax Plasmodium Malariae Plasmodium ovale Plasmodium knowlesi
• Siklus hidup parasit malaria
Sel darah merah yang terinfeksi malaria
Plasmodium vivax • Eritrosit membesar, Eritrosit membesar 2. Terdapat titik schuffner disekitar parasit 3. Titik Schuffner bentuknya halus dan tersebar merata di sekitar parasit 4. Stadium yang ditemukan : trofozoit, skizon dan gametosit (semua stadium)
• tadium trofozoit Ciri-ciri : - eritrosit membesar - bentuk cincin ( besarnya 1/3 eritrosit) - mulai tampak titik schuffner.
Stadium skizon Ciri-ciri : - eritrosit : membesar - jumlah inti 12 - 24 - pigmen : kuning tengguli berkumpul - titik schuffner masih tampak dibagian pinggir eritrosit Stadium makrogametosit Ciri-ciri : - eritrosit membesar - inti kecil, padat, pigmen tersebar - protoplasma biru - titik schuffner masih tampak di pinggir
• Paciiparum, dapat diilakukan dgn pewarnaan giemsa, dpt dilihat dgn mikroskop dgn pembesaran 1000 x (objektif 100 x dan okuler 10 kali)
• Plasmodium falciparum Yang harus diperhatikan dlm pemeriksaan parasit ini yaitu : 1. Eritrosit tidak membesar 2. Terdapat titik maurer disekitar parasit 3. Bentuk titik Maurer kasar 4. Stadium yang ditemukan umumnya trofozoit dan gametosit 5. Bila ditemukan stadium skizon di sediaan darah tepi menandakan adanya infeksi berat
• Stadium skizon (jarang ditetmukan di dlm darah tepi) Ciri-ciri: - Eritrosit tidak membesar - Parasit: jumlah inti 2 - 24 - pigmen sudah menggumpal berwarna hitam
Stadium gametozit ; eritrosit tidak membesar - Parasit: * bentuk pisang agak lonjong atau seperti sosis (mikrogametosit) * plasma biru atau merah muda (mikrogametosit) * inti padat (kalau mikrogametosit tdk padat) * pigmen di sekitar inti atau tersebar (mikrogametosit )
Manifestasi klinik Malaria
perkembangan • Terdapat lima jenis parasit plasmodium. Kasus yang paling banyak ditemukan di Indonesia disebabkan oleh Plasmodium falciparum dan Plasmodium vivax. Kedua jenis parasit ini adalah penyebab malaria yang paling umum. Plasmodium falciparum bertanggung jawab atas sebagian besar kematian yang diakibatkan oleh malaria. Plasmodium vivax bisa mengakibatkan penderita yang telah sembuh menjadi sakit lagi karena parasit ini dapat diam bersembunyi di dalam organ hati manusia sebelum menjadi aktif lagi. • Tiga parasit yang lainnya adalah Plasmodium ovale, Plasmodium malariae dan Plasmodium knowlesi. Ketiga parasit ini adalah jenis yang jarang ditemui kejadiannya di Indonesia.
– Plasmodium falciparum penyebab malaria tropika yang menimbulkan demam tiap 24 -48 jam, – Plasmodium vivax penyebab malaria tertiana yang menimbulkan demam tiap hari ke 3 – Plasmodium malariae penyebab malaria kuartana yang menimbulkan demam tiap hari ke 4 – Plasmodium ovale penyebab malaria ovale, memberikan infeksi yang paling ringan dan sering sembuh spontan tanpa pengobatan (Harijanto, 2010).
Gejala klinik Selain itu, pada infeksi malaria terdapat gejala klasik malaria akut yang sering di sebut Trias Malaria, secara berurutan : • Periode dingin. Stadium ini mulai dengan menggigil, kulit dingin dan kering. Gigi gemeretak dan penderita biasanya menutup tubuhnya dengan selimut yang tersedia. Nadi cepat tetapi lemah. Bibir dan jari pucat kebiru-biruan, kulit kering dan pucat. Stadium ini berlangsung antara 15 menit sampai 1 jam. diikuti meningkatnya temperatur. • Periode demam Setelah merasa kedinginan, pada stadium ini penderita merasa kepanasan. Suhu badan dapat meningkat sampai 40°C atau lebih. Muka merah, kulit kering dan terasa sangat panas seperti terbakar, sakit kepala, nadi cepat, respirasi meningkat, muntah-muntah dan dapat terjadi syok (tekanan darah turun) bahkan sampai terjadi kejang (pada anak). Stadium ini berlangsung lebih lama dari periode dingin, antara 2 sampai 4 jam. Demam disebabkan oleh pecahnya sison darah yang telah matang dan masuknya merozoit ke dalam aliran darah. Dalam pembuluh darah pada organ-organ tubuh tersebut.
Periode Berkeringat. Pada periode ini penderita berkeringat banyak sekali sampai tempat tidurnya basah. Temperatur turun dan penderita merasa capek dan biasanya dapat tidur nyenyak. Pada saat bangun dari tidur merasa lemah tetapi tidak ada gejala lain, stadium ini berlangsung antara 2 sampai 4 jam. Gejala-gejala yang disebutkan di atas tidak selalu sama pada setiap penderita, tergantung pada spesies parasit dan umur dari penderita, gejala klinis yang berat biasanya terjadi pada malaria tropika. Hal ini disebabkan oleh adanya kecenderungan parasit (bentuk trofosoit dan sison). Untuk berkumpul pada pembuluh darah organ tubuh seperti otak, hati dan ginjal sehingga menyebabkan tersumbatnya
• Penyebaran penyakit malaria pada manusia dilakukan oleh nyamuk Anopheles betina yang sudah terinfeksi parasit Plasmodium. Nyamuk akan terinfeksi jika menggigit penderita malaria. Nyamuk ini kemudian akan menyebarkan parasit pada orang lain melalui gigitan. • Parasit akan masuk ke aliran darah dan bergerak ke organ hati. Infeksi akan terjadi dan berkembang di organ hati. Dari situ, parasit akan masuk kembali ke aliran darah dan menyerang sel darah merah. Parasit akan memanfaatkan sel darah merah sebagai tempat berkembang biak. • Jika sel darah merah sudah penuh terisi dengan parasit malaria, sel tersebut akan meletus sehingga lebih banyak lagi parasit yang tersebar di dalam aliran darah. Sel darah merah yang terinfeksi meletus tiap dua hingga tiga hari. Ketika ini terjadi, penderita akan mengalami gejala seperti demam, menggigil, dan berkeringat.
Karena parasit yang menyebabkan malaria memengaruhi sel darah merah, orang juga bisa terserang malaria jika terjadi pajanan terhadap darah yang terinfeksi. Meski jarang terjadi beberapa proses berikut bisa menularkan infeksi malaria: • Dari ibu hamil yang terkena malaria ke janin yang dikandungnya. • Proses transfusi darah. • Berbagi jarum suntik dengan penderita malaria.
• Ketika berada di daerah endemik malaria, pendatang lebih rentan terserang malaria. Sistem kekebalan tubuh mereka tidak sebaik penduduk daerah endemik malaria dalam melawan parasit. Karena itu disarankan untuk mengonsumsi obat antimalaria bagi Anda yang ingin bepergian ke daerah endemik malaria.
Diagnosa malaria • Diagnosis malaria umumnya didasarkan pada manifestasi klinis (termasuk anamnesis), uji imunoserologis dan ditemukannya parasit (plasmodium) dalam darah penderita. Manifestasi klinis demam malaria seringkali tidak khas dan menyerupai penyakit infeksi lain seperti demam dengue dan demam tifoid, sehingga sulit dilakukan diagnosa dengan mengandalkan pengamatan secara klinis saja, namun perlu dilakukan pemeriksaan laboratorium untuk menunjang diagnosis malaria sedini mungkin.
Syarat-syarat pengambilan sampel Pemeriksaan mikroskopis membutuhkan syarat-syarat tertentu agar di peroleh nilai diagnostik yang tinggi yaitu dengan sensivitas dan spesifitas yang tinggi. Syarat-syarat tersebut meliputi: • Waktu pengambilan sampel harus tepat yaitu pada akhir peroide demam memasuki periode berkeringat karena pada periode ini jumlah trofozoit mencapai jumlah maksimal dalam sirkulasi. • Volume darah yang diambil sebagai sampel cukup untuk sediaan darah tipis ( 1 – 1, 5 mikroliter) dan sediaan darah tebal (3 -4 mikroliter) • Kualitas preparat harus baik agar terjamin kualitas identifikasi spesies plasmodium dengan tepat (Purwaningsih, 2000)